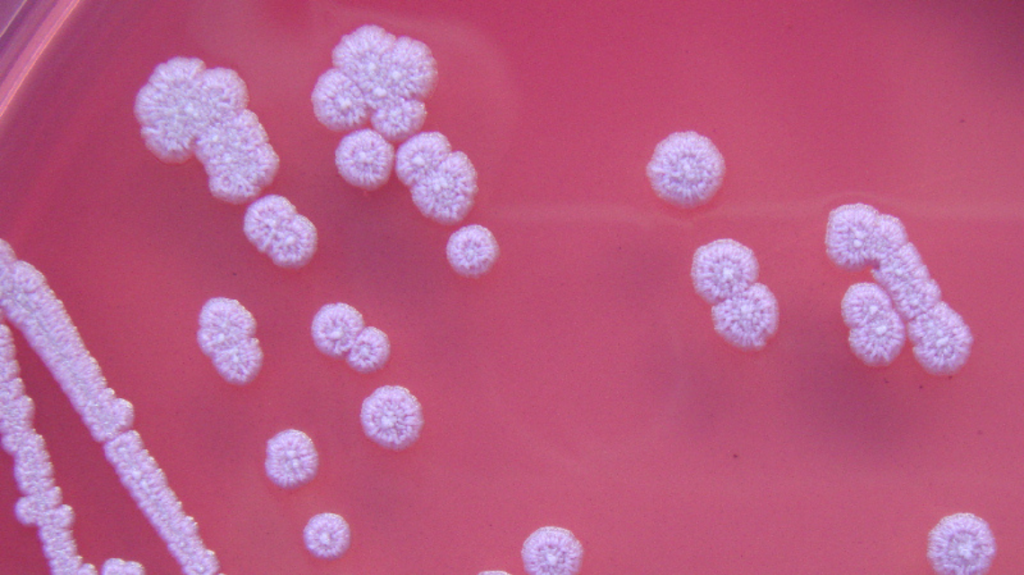
Times 5 magnification of bacteria colonies of Burkholderia pseudomallei on Ashdown
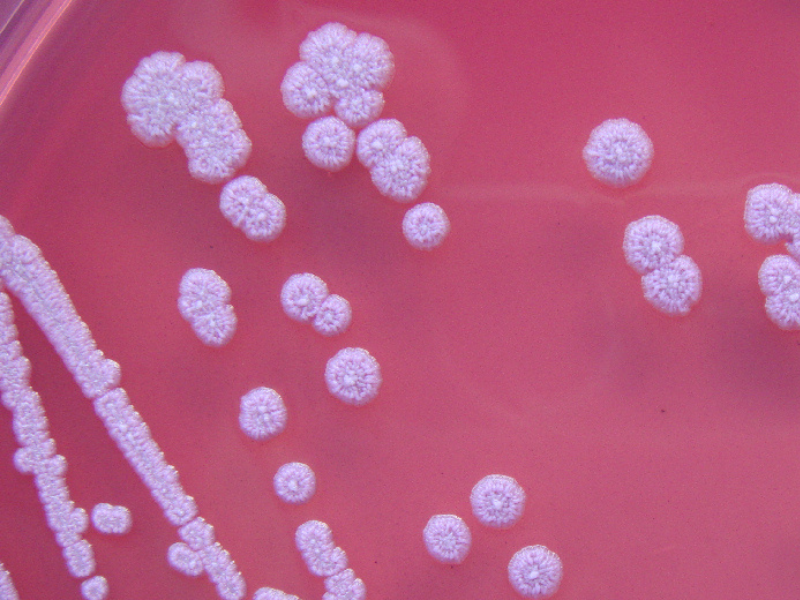
800x60063

For the first time, a possibly fatal strain of bacteria has been identified within the United States’s soil and water, causing the Centers for Disease Control and Prevention to ask healthcare professionals to look out for signs and symptoms in patients.
The bacteria, known as Burkholderia pseudomallei, causes a rare disease named melioidosis that has killed 10 to 50% of individuals it infected in various outbreaks worldwide, the CDC wrote in a health advisory.
The CDC stated that the bacteria were found in soil and water in the Gulf Coast region of southern Mississippi during an investigation of two unrelated melioidosis cases, which were identified in 2020 and 2022. Both individuals were hospitalized and recuperated after treatment with antibiotics, it stated.
The CDC stated that the bacteria generally reside in tropical and subtropical climates outside the continental United States and are currently considered endemic in specific locations of the region.
Look out for fevers and headaches
Individuals can get contaminated with Burkholderia pseudomallei via direct exposure to infected soil or water via cuts in the skin, breathing, or consumption. However, the danger of spreading from person to person is “extremely low,” the CDC claimed.
Any organ, including the brain, is prone to melioidosis. Symptoms differ based on the part of the body impacted.
Symptoms consist of:
- Fever;
- Localized pain or swelling;
- Ulcers;
- Abscesses;
- Coughing;
- Chest pain;
- Trouble breathing;
- Loss of appetite;
- Loss of weight;
- Stomach discomfort;
- Muscle or joint pain;
- Confusion;
- Headache;
- Seizures.
The CDC asked healthcare workers to take into consideration the illness when patients present these signs.
Typically, it takes two to four weeks after exposure for symptoms to develop; however, it can be as fast as an hour. In 5% of patients, symptoms can be seen years after exposure, according to the CDC.
Individuals with specific hidden health problems are most likely to get ill or pass away from melioidosis. These consist of diabetes, severe alcohol use, chronic lung disease, chronic kidney disease, and any problem that weakens the immune system.
A bacteria not typically from the US
The two individuals in Mississippi that became infected with the bacteria had not journeyed outside the United States
Burkholderia pseudomallei is typically found in Thailand, north Australia, and Puerto Rico.
Approximately 12 melioidosis cases are reported to the CDC yearly; however, most patients have recently journeyed to a nation where the bacteria is endemic, the CDC stated. Both Mississippi cases had not traveled outside the United States, it claimed.
The samples indicate the bacteria has been present in the region since 2020; however, it is uncertain how long and if it has infected other parts of the United States.
Originally published by: Insider